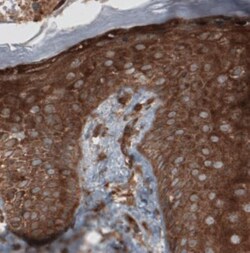
CARS Antibody (CL2310), Novus Biologicals 0.1 mL | Buy Online | Novus Biologicals | Fisher Scientific

missing translation for 'onlineSavingsMsg'
Learn More
Learn More
Beschreibung
CARS Monoclonal specifically detects CARS in Human samples. It is validated for Western Blot, Immunohistochemistry, Immunohistochemistry-Paraffin.

Spezifikation
Spezifikation
| Antigen | CARS |
| Applications | Western Blot, Immunohistochemistry |
| Classification | Monoclonal |
| Clone | CL2310 |
| Conjugate | Unconjugated |
| Dilution | Western Blot 1:500-1:1000, Immunohistochemistry 1:1000 - 1:2500, Immunohistochemistry-Paraffin 1:1000-1:2500 |
| Formulation | PBS (pH 7.2) and 40% Glycerol with 0.02% Sodium Azide |
| Gene Accession No. | A8MVQ3 |
| Gene Alias | CARS1, CysRS, cysteine translase, cysteine tRNA ligase 1, cytoplasmic, Cysteine--tRNA ligase, cysteinyl-tRNA synthetase, cysteinyl-tRNA synthetase, cytoplasmic, EC 6.1.1, EC 6.1.1.16, MGC:11246 |
| Gene Symbols | CARS |
| Mehr anzeigen |
For Research Use Only
Name des Produkts
Indem Sie auf Absenden klicken, erklären Sie sich damit einverstanden, dass Fisher Scientific sich mit Ihnen in Verbindung setzen kann, um Ihr Feedback in diesem Formular zu bearbeiten. Wir werden Ihre Informationen nicht für andere Zwecke weitergeben. Alle bereitgestellten Kontaktinformationen werden in Übereinstimmung mit unserer Datenschutzrichtlinie aufbewahrt. Datenschutzrichtlinie.
Haben Sie Verbesserungsvorschläge?